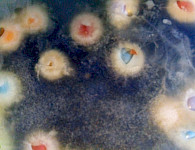

AMAZONIEN2026


In the year1541,the Spaniard Francisco de Orellana set out from the Andes in search of"El Dorado". But the Conquistador does not discover an empire of gold, but a mighty river: the Amazon. In the 16th century, the greed for precious metals, land and slaves drives the Europeans deeper and deeper into the interior of the South American continent. The search for gold leads to the worst destruction of the most species-rich habitat on earth.200 years ago,when Alexander von Humboldt explores the Amazon, he is fascinated by this area. With his observations and descriptions, Humboldt recognizes a concept of nature, the web of life in which everything is interconnected.Humboldt is shocked to learn how the "Conquistadors" could cause such drastic destruction to man and nature in a such short time.During my visits to the Amazon basin, I myself have also seen it. Here, the beauty of nature still exists, but the greed for gold and "black gold" continues to drive the destruction of the Amazon with all its might.Where once there was primeval forest now stand green wastelands of pampas grass, where millions of cows graze and provide cheap meat for the hungry fast food corporations. Palm oil and soy plantations stretch for miles and miles, on land once covered by the mighty jungle.There are still huge forests, few indigenous peoples still live originally, wonderful birds sing and Jaguars roam the jungle. How much longer is uncertain.My "AMAZONIA" shows a longing for a lost paradise